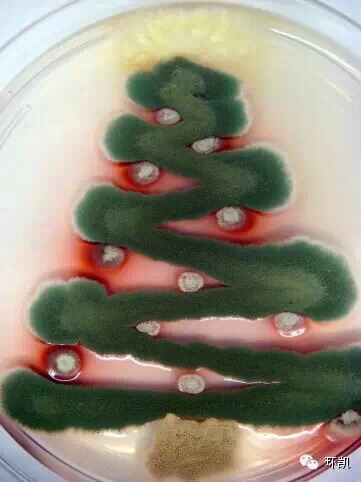

微生物版的圣诞节,很神奇!
2014-12-25 佚名 生物吧
圣诞节了,在这寒冷的冬天里面,微生物也可以用来画出美丽的圣诞树呢,小小的菌落,竟然可以勾勒出如此绚丽多彩的图片。 用真菌形成的圣诞树 边缘和球:费希新萨托菌(Neosartorya fischeri) 帽子:马尔尼菲青霉菌(Penicillium marneffei) Ho,Ho,Ho:黄曲霉(Aspergillus flavus) 拍摄者:Steph
圣诞节了,在这寒冷的冬天里面,微生物也可以用来画出美丽的圣诞树呢,小小的菌落,竟然可以勾勒出如此绚丽多彩的图片。

用真菌形成的圣诞树

边缘和球:费希新萨托菌(Neosartorya fischeri)
帽子:马尔尼菲青霉菌(Penicillium marneffei)
Ho,Ho,Ho:黄曲霉(Aspergillus flavus)
拍摄者:Stephanie Mounaud,来自 J. Craig Venter Institute.

星: 柄篮状菌(Talaromyces stipitatus)
树:小巢状曲菌 (Aspergillus nidulans)
装饰:马尔尼菲青霉菌(Penicillium marneffei)
树干:土曲霉(Aspergillus terreus)
图片拍摄:Stephanie Mounaud, 来自 J. Craig Venter Institute.

帽子、眼睛、嘴、扣子:黑曲霉(Aspergillus niger)
胳膊:小巢状曲霉(Aspergillus nidulans)
鼻子:土曲霉和马尔尼菲青霉菌(Aspergillus terreus with Penicillium marneffei)
身体:费希新萨托 菌(Neosartorya fischeri)
图片拍摄:Stephanie Mounaud, 来自 J. Craig Venter Institute.
本网站所有内容来源注明为“梅斯医学”或“MedSci原创”的文字、图片和音视频资料,版权均属于梅斯医学所有。非经授权,任何媒体、网站或个人不得转载,授权转载时须注明来源为“梅斯医学”。其它来源的文章系转载文章,或“梅斯号”自媒体发布的文章,仅系出于传递更多信息之目的,本站仅负责审核内容合规,其内容不代表本站立场,本站不负责内容的准确性和版权。如果存在侵权、或不希望被转载的媒体或个人可与我们联系,我们将立即进行删除处理。
在此留言










#圣诞节#
49
#微生物#
41